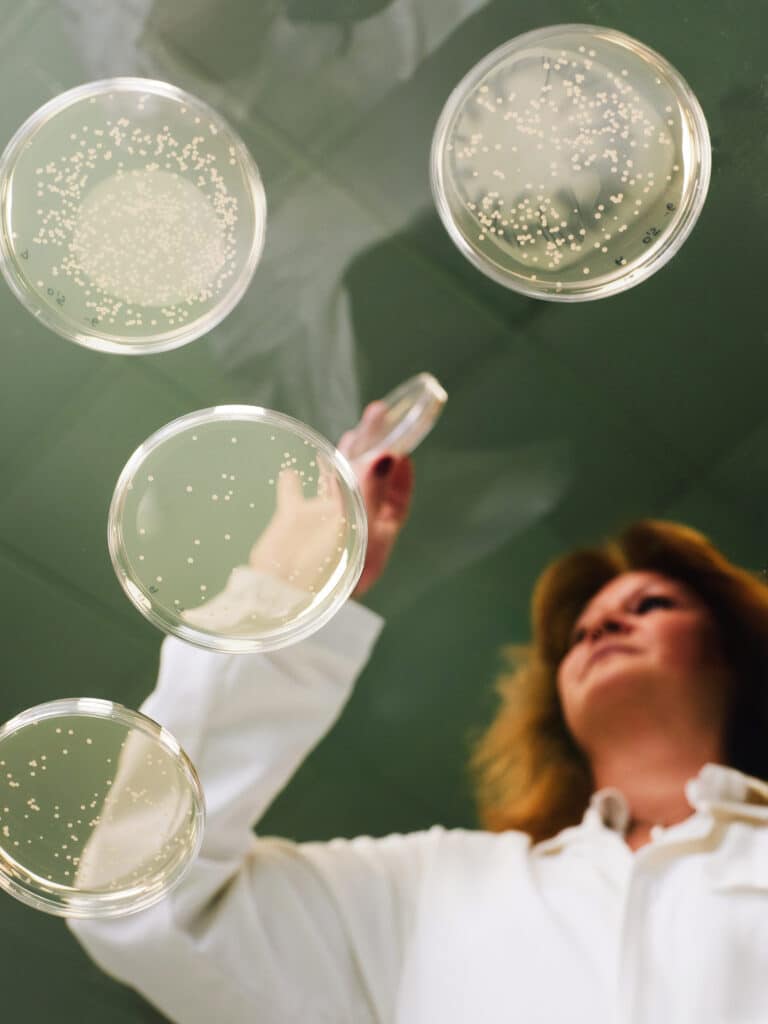

We have one goal: to raise the standard of human health
We partner with nutraceutical, pharmaceutical, and functional food & beverage brands to create next-gen health products. By combining nature’s intelligence with scientific excellence, we’re raising the bar in human health.
From bacteria strain to documented scientific solutions
We provide fully integrated manufacturing – covering everything from raw materials to finished private-label products, and even bespoke contract manufacturing. By working closely with you, we turn challenges and requests into effective, market-ready solutions.

Our science answers consumer needs
Our scientific knowledge and discoveries, combined with consumer research and market insights, inform the choices we make and guide innovation together with our partners and customers.
Growing together
With global insight, regulatory expertise, and large-scale pharma-grade manufacturing, we ensure a reliable, high-quality supply chain. Combined with our application know-how, we deliver complete turnkey solutions. This makes development smoother, faster, and more effective, so our partners can stay ahead.
Harness the power of microorganisms
As experts in human health innovation, we are inspired by nature’s biological power to drive innovation. At the intersection of scientific excellence and biology, we create premium, proven, bio-health solutions within Nutritional Yeast, Biotics, and Active Ingredients.

Why do we Think like Nature?
At Gnosis by Lesaffre, we believe that good health must evolve from being reactive to being preemptive. By harnessing the power of microorganisms and learning from nature’s intelligence, we create proactive, sustainable solutions that help people live stronger, longer and happier lives.
In this video, our teams share what Think Like Nature means to them. Their perspectives reflect our holistic approach, where every innovation is inspired by nature’s ecosystem, guided by science, and designed to positively impact both human and planetary health.
Together, by thinking like nature, we can raise the standard of human health.
Raising Human Health
At Gnosis by Lesaffre we are on a mission to raise the standard of human health. In this video, our teams share what Raise Human Health means to them. Their voices and experiences reflect our holistic approach, where health is seen as a balance between body, mind and environment, and where proactive solutions help people live stronger, longer and happier lives.

170 years of fermentation expertise
As an integrated part of the Lesaffre family, we are experts in biotransformation, tapping into over 170 years of expertise in fermentation and biotechnological innovation.
Our close family relationship gives us and our partners a powerful advantage, with a robust foundation of scientific expertise, operational excellence and a shared vision of sustainability and innovation.
As part of the Lesaffre family, we share a bold mission: to nourish people and planet. United by strong values and an entrepreneurial spirit, we are the reference in bio-transformation, addressing unmet health needs. The Lesaffre Group, with a €2.7 billion turnover, is present on every continent and employs 11,000 people representing 90 nationalities.

Commitment to customers
Our commitment to science-driven innovation translates into trusted solutions that deliver proven efficacy and quality. For our partners and customers, this means confidence in every collaboration. Together, we Think like Nature and co-create value – turning insight into impact, and scientific discovery into products that make a real difference in people’s lives.

A broad portfolio to meet every individual’s evolving needs
From the very start of life through to healthy aging, our scientifically researched and clinically tested bioscience health solutions help strengthen the human body and mind.

Our Portfolio
We believe in science through the responsible and sustainable processes of fermentation and biocatalysis to provide products and solutions made from the highest quality source...

Our Media Features
Our recent appearances in the media showcase innovations in our science, our ingredients, and our organization.

Our Science
Browse our collection of publications—all designed to share complex science in approachable ways. Dive in and download what interests you whenever inspiration strikes.
Strengths and capabilities
Our health solutions are backed by strong science and clinical validation. We work with a global network of academia to have our solutions studied with the strictest scientific rigor. We have partners who utilize the latest scientific technology ensuring our solutions are precise, safe, and proven effective. Our core capabilities and strengths include:
- Formulation, substantiation, and clinical studies
- Supply chain and customer service
- Production and processes
- Quality and regulatory

Latest news
Any where, any time
With operations across the entire world, and production facilities and offices on three continents, Gnosis can deliver solutions for the pharmaceutical, nutraceutical, and functional food and beverage markets, when and where you need it.